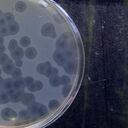

La genética del SARS-CoV-2 cambia constantemente y sus 29.903 caracteres en cada copia pueden mutar o alterase.
Las variantes tienen una “matrícula” que las identifica y no es el país en donde se detectó. Es decir, tienen una letra, tres números y otra letra (E848K). La primera letra representa que aminoácido cambia, los números son la posición del genoma del virus y la última letra representa el nuevo aminoácido, pero antes de la primera letra hay otra que representa a que parte del virus afecta el gen.
A finales de 2020 se conoció la cepa británica y según estudios preliminares “escapa de la detección y neutralización de los anticuerpos” y de acuerdo con el ministro británico, Boris Johnson, hay evidencias de que es más letal, ya que con la variante anterior morían 10 de cada 1.000 personas y con la nueva fallecen 13 de cada 1.000, según información preliminar del Grupo Asesor de Virus Emergentes (Nertag).

Pero, los expertos en salud británicos expresaron su sorpresa por los comentarios de Johnson, porque la directora de la Sanidad Pública Británica, Yvonne Doyle, explicó a la BBC que todavía “no está absolutamente claro” que esa variante sea más letal. “Hay alguna evidencia”, reconoció, “pero es una evidencia muy temprana. Todavía es demasiado pronto como para asegurar algo”.
Hay que señalar que se asocian las mutaciones a su capacidad de transmitirse entre personas. Sin embargo, la viróloga María Bernabeu, le explicó Newtral.es que puede ocurrir un tiempo considerable para que se note el impacto total de las variantes.
Los Centros para el Control y Prevención de Enfermedades (CDC) advierten que “con la vacunación contra el virus las trayectorias tempranas de la epidemia no cambian”, pero para el profesor Ravi Gupta, un microbiólogo de la Universidad de Cambridge, aseguró que los fabricantes de las vacunas contra el coronavirus deben desarrollar otras para combatir las mutaciones que se han registrado hasta el momento.

No obstante, la vacuna contra el coronavirus desarrollada por Pfizer y BioNTech sería efectiva contra la cepa detectada en Reino Unido. Además, que la vacuna era efectiva contra una mutación clave llamada N501Y, la cual se encuentra en ambas nuevas cepas que se están propagando en el Reino Unido, Sudáfrica, entre otros países.
Sin embargo, el virólogo José Antonio López-Guerrero dijo que la mutación que se extendió por Sudáfrica (E484K) “preocupa porque, no sólo se asocia a una mayor capacidad para contagiar y reproducirse, sino que parece escaparse de la neutralización de los anticuerpos entrenados con otras variantes”.
Pero, tal como la británica, la variante sudafricana o la brasileña “aprendieron” a escaparse de los anticuerpos lo cual despista a las defensas. O sea, es como si se disfrazaran para que no las persigan.
Bernabeu advirtió: “estamos siguiendo ahora a tres variantes, pero seguramente van a aparecer más en el futuro, es importante que estemos un paso por delante de la evolución del virus. Tenemos que secuenciar más”.
De hecho, para el virólogo de la Universidad de Massachusetts Worcester (EE. UU.) en un artículo de Nature “las vacunas seguirán siendo efectivas para las cosas que realmente importan: evitar que la gente enferme mortalmente”.
Asimismo, la inmunóloga y epidemióloga Margarita del Val dijo en Newtral.es: “La vacuna es una barrera y eso puede hacer que proliferen variantes que se resistan a la vacunación. El virus se enfrenta a una situación dura, que es la presencia de anticuerpos, pero no más dura que cuando se ha pasado la infección de manera natural”.
Finalmente, hay que recordar que en el mundo hay 100 millones de casos de coronavirus, más de 2,1 personas han perdido la vida y más de 55 millones se han recuperado de la enfermad que apareció en Wuhan (China) en diciembre de 2019.
